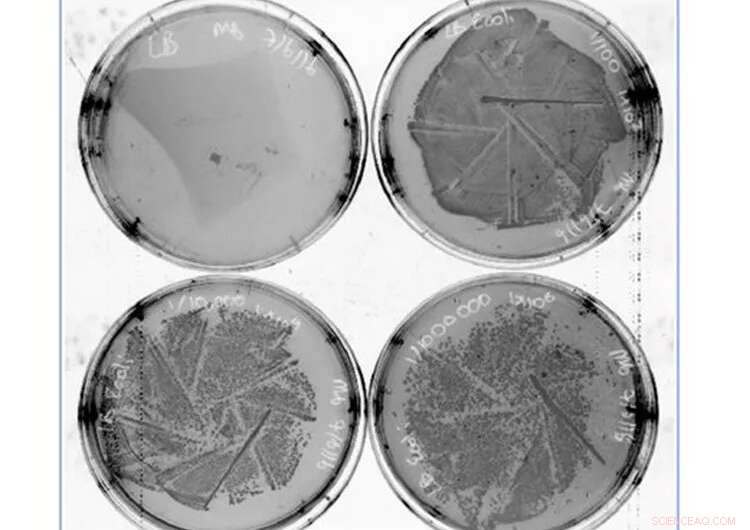
University of Queensland Unveils Nanoworm Coating to Neutralize COVID-19

Testing the coating. Credit: University of Queensland
An antiviral surface coating technology sprayed on face masks could provide an extra layer of protection against COVID-19 and the flu.
The coating developed at The University of Queensland has already proven effective in killing the virus that causes COVID-19, and shows promise as a barrier against transmission on surfaces and face masks.
UQ's Australian Institute for Bioengineering and Nanotechnology researcher Professor Michael Monteiro said the water-based coating deployed worm-like structures that attack the virus.
"When surgical masks were sprayed with these 'nanoworms," it resulted in complete inactivation of the Alpha variant of SARS-CoV-2 and influenza A," Professor Monteiro said.
The coating was developed with Boeing as a joint research project, and was tested at the Peter Doherty Institute for Infection and Immunity at The University of Melbourne.
"These polymer 'nanoworms' rupture the membrane of virus droplets transmitted through coughing, sneezing or saliva and damage their RNA," Professor Monteiro said.
"The chemistry involved is versatile, so the coating can be readily redesigned to target emerging viruses and aid in controlling future pandemics."
Professor Monteiro said face masks would continue to be an important part of helping prevent or reduce community transmission of COVID-19.
"Antiviral coatings applied on mask surfaces could reduce infection and provide long-lasting control measures to eliminate both surface and aerosolised transmission," he said.
"We know that COVID-19 remains infectious for many hours or days on some surfaces, and provides a direct route to infection.
"Therefore, there is greater emphasis on eliminating both surface and airborne transmission to complement vaccination of the population to stop the current pandemic."
The coating is environmentally friendly, water-based and its synthesis aligns with manufacturing techniques used in the paint and coatings industry.
The research is published in ACS Nano.